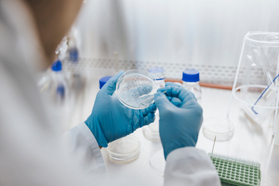
A Robust Alternative To Plasmid DNA For AAV Production GettyImages-1347856192-plasmid-dna-development-research-lab

ABOUT VIRALGEN
Viralgen’s purpose is to make gene therapy accessible to all who live with a genetic disease.
Viralgen is a CDMO born as a joint venture between AskBio and Columbus Venture Partners, combining decades of technology and drug development experience in multiple platforms to support best-in-class service offerings to the gene therapy market.
Viralgen was created in 2017 to respond to the unmet need for manufacturing of gene therapies, with the goal to help broaden access to these life-saving therapeutics and to contribute to the advancement of health and human welfare around the world. We specialize in the production of rAAV viral vectors, and have built an optimized facility in San Sebastian (Spain) that maximizes throughput and efficiency of our proprietary Pro10™ suspension manufacturing platform, enabling industry-leading scalability, reproducibility, and speed to market.
Through our superior technology platform, we deliver industry-leading titers and cGMP-certified quality for all AAV serotypes to our client partners, optimize the cost-of-goods and accelerate clinical development and commercialization of life-saving genetic medicines.
In October 2020, Bayer acquired AskBio, giving the project a definitive boost. We will continue to operate with the same brand, corporate culture and current management, adding the financial and technical capacity of the multinational. This will enable us to fulfill more effectively our founding purpose of providing healing through gene therapy to patients who, until now, did not have it.
CONTACT INFORMATION
Viralgen
Paseo Mikeletegi, 83
San Sebastián, 20009
SPAIN
Phone: +34 943 47 77 33